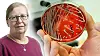
Växande fara. Allt fler bakterier utvecklar resistens mot antibiotika – ett allvarligt hot mot folkhälsan även i Sverige.

Ledare
Antibiotikafrågan kräver sin Greta
Växande fara. Allt fler bakterier utvecklar resistens mot antibiotika – ett allvarligt hot mot folkhälsan även i Sverige.
Cornelius Poppe
Hundra personer i EU dör varje dag i onödan. De har drabbats av en infektion som orsakats av en bakterie som utvecklat motståndskraft mot antibiotika. Vi är på väg tillbaka till den situation som rådde innan penicillinet gjorde sitt intåg i läkarnas arsenal, när sådant som vi vant oss att se som botbara sjukdomar återigen blir livshotande.